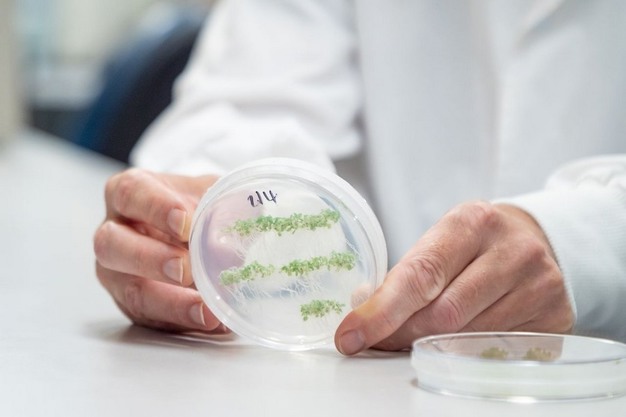

Onderzoekers van de University of Queensland in Australië hebben ontdekt dat biopesticiden op basis van dubbelstrengs RNA (dsRNA) die op bladeren worden gespoten, zich kunnen verplaatsen tot in de wortels van de plant.
Het onderzoek, geleid door dr. Chris Brosnan van de Queensland Alliance for Agriculture and Food Innovation (QAAFI), weerlegt ook een lang bestaande veronderstelling dat dsRNA direct in plantcellen binnendringt.
"In plaats daarvan hebben we bij meerdere plantensoorten aangetoond dat dsRNA, wanneer het op een blad wordt gespoten, mobiel is en zich tussen cellen en door de hele plant verplaatst, inclusief naar de wortels," aldus Brosnan.
"Als we een pathogeen willen bestrijden, biedt deze spuittechnologie een reële kans van slagen, omdat het dsRNA systemisch kan bewegen en zo in contact komt met de pathogenen die het moet uitschakelen."
 © Megan PopeDr. Chris Brosnan en dr. Don Gardiner in het QAAFI-laboratorium
© Megan PopeDr. Chris Brosnan en dr. Don Gardiner in het QAAFI-laboratorium
DsRNA is een molecule die genen kan reguleren of RNA-interferentie (RNAi) kan activeren bij doelwitsoorten zoals virussen, bacteriën en schimmels. Biopesticiden gebaseerd op RNAi zijn een opkomende technologie en vormen een duurzaam alternatief voor chemische gewasbeschermingsmiddelen.
Wanneer plagen of pathogenen dsRNA opnemen, worden essentiële genen uitgeschakeld, waardoor de plaag sterft zonder schade aan de plant of andere nuttige organismen te veroorzaken.
© Megan Pope
© Megan Pope
Dr. Donald Gardiner van QAAFI benadrukte het belang van de bevindingen: "Dit onderzoek verandert het dogma over de stabiliteit, opname en beweging van dsRNA, wat cruciaal is voor de verdere ontwikkeling van deze technologie," zei Gardiner.
"Er zijn momenteel geen effectieve spuitbare producten om plagen en pathogenen ondergronds aan te pakken. Het is een uitdaging om iets beschermends in de wortels van planten te krijgen. Als we RNA op een blad kunnen spuiten en het intact door de plantweefsels naar de wortels kan laten bewegen, biedt dat een belangrijke mogelijkheid om moeilijk bereikbare plagen en pathogenen te bestrijden."
 © Megan Pope
© Megan Pope
Brosnan gaf aan dat het volgende doel van het team is om wortelorganismen te identificeren die bijzonder gevoelig zijn voor dsRNA.
"Een van de uitdagingen bij de ontwikkeling van effectieve RNA-gebaseerde technologieën is de instabiliteit van RNA in de bodem," zei hij. "Onze bevinding kan dit probleem helpen verminderen, maar we moeten nog begrijpen hoe dit verplaatste RNA vervolgens wordt overgedragen op gevoelige organismen. Een mogelijke doelgroep zijn nematoden, een belangrijke plaag die granen, katoen en veel belangrijke tuinbouwgewassen aantast."

Voor meer informatie:
The University of Queensland
uq.edu.au/










